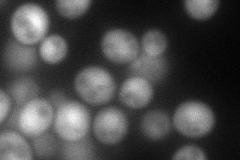
YML036W
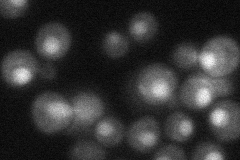
YML036W
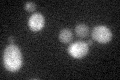
YML036W
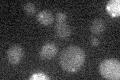
YML036W

View description
Protein involved in telomere uncapping and elongation as component of the KEOPS protein complex with Bud32p, Kae1p, Pcc1p, and Gon7p; also shown to be a component of the EKC protein complex; homolog of human CGI-121
Localization:
Intensity:
Fold change:
Significance:
-
C’ GFP library in SD

below threshold18.04 -
N' NOP1pr-GFP in SD

cytosol,nucleus96.7401 -
N' TEF2pr-mCherry in SD
nucleus129.092 -
N' NATIVEpr-GFP in SD
nucleus39.5652 -
N' TEF2pr-VC and Cyto-VN in SD

cytosol,nucleus37.5861 -
C’ GFP library in SD+DTT
cytosol15.180.84No -
C’ GFP library in SD+H2O2

cytosol16.150.89No -
C’ GFP library in Starvation Media
cytosol16.480.91No -
C’ GFP library on the background of Pup2-DaMP

below threshold -
C’ GFP library on the background of CCT mutant

below threshold17.36120.962121No
